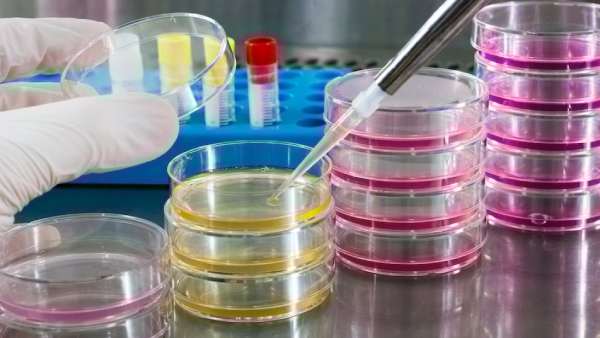
நோபல் விஞ்ஞானி

சாகா வரம் பெற பிளான்.. கோடிகளை வாரி இறைத்த அமேசான் ஜெப் பெஸோஸ்.. மலைக்க வைக்கும் ஆராய்ச்சி!
நியூயார்க்: பணம் இருந்தால் எதை வேண்டுமானாலும் வாங்கலாம்.. சாகா வரத்தை பெற முடியுமா என்று பலர் கேட்பதுண்டு. அந்த சாகா வரம் பெறும் திட்டத்தில் களமிறங்கிவிட்டார் அமேசான் நிறுவனர் ஜெப் பெஸோஸ். ஆம் மனித இனம் மரணம் என்ற ஒன்றை சந்திக்காமல் எப்போதும் இளமையாக இருப்பதற்கான ஆராய்ச்சிக்கு ஜெப் பெஸோஸ் கோடிகளை கொட்டிக்கொடுத்துள்ளார்... அது என்ன ஆராய்ச்சி என்று பார்க்கலாம்.
உலக வரலாற்றில் பல முறை இது போன்ற ஆராய்ச்சிகள் நடந்து உள்ளன. பண்டைய காலங்களில் மன்னர்கள் பலர் தாங்கள் மரணம் அடைய கூடாது என்பதற்காக சாகா வரம் பெறும் பூஜைகளை நடத்தியது உண்டு. அதன்பின் பல வெளிநாட்டு மன்னர்கள், ஆராய்ச்சியாளர்கள் அப்போது சாகா வரம் பெறுவதற்கான ஆராய்ச்சிகளை மேற்கொண்டு தோல்வி அடைந்துள்ளனர்.
மனித குலம் இதுவரை சாகா வரம் என்னும் இலக்கை அடையவே இல்லை. 20ம் நூற்றாண்டிற்கு பின் பல முறை இதற்கான ஆராய்ச்சிகள் நடத்தப்பட்டுவிட்டது. பல நாடுகளில் இப்போதும் பல கோடி முதலீடுகளை போட்டு ஆராய்ச்சிகள் நடந்து கொண்டு இருக்கின்றன. அப்படி ஒரு சாகா வரம் பெறும் ஆராய்ச்சியில்தான் அமேசான் நிறுவனர் ஜெப் பெஸோஸ் குதித்து இருக்கிறார்.

என்ன ஆராய்ச்சி?
அமெரிக்காவை சேர்ந்த அட்லாஸ் லேப்ஸ் என்ற நிறுவனத்தில் ஜெப் பெஸோஸ் பல கோடிகளை முதலீடாக செய்துள்ளார். ஆனால் இதில் அவரின் முதலீடு எவ்வளவு என்று உறுதியாக தெரியவில்லை என்றாலும், நிறுவனத்தின் மதிப்பில் பாதிக்கும் அதிகமாக ஜெப் பெஸோஸ் முதலீடு செய்துள்ளார் என்று கூறப்படுகிறது. இந்த நிறுவனம் தற்போது மனித குலத்திற்கு சாகா வரம் அளிக்கும் ஆராய்ச்சியை செய்து கொண்டு இருக்கிறது. ஆம் மனிதர்கள் சாகாமல் எப்போதும் இளமையாகவே இருக்க வைப்பதற்கான ஆராய்ச்சிகளை இந்த நிறுவனம் செய்து கொண்டு இருக்கிறது.

வயது ஆவது எப்படி?
பொதுவாக மனிதர்களுக்கு உடலில் இருக்கும் செல்கள் வளர்ந்து அது பெரிதாகி பல பிரிவுகளாக பிரிந்து அந்த செல்களும் வளர்ந்து பின் அது செயல் இழந்து இறந்து மடியும். இது சுழற்சி முறையில் உடலில் நடந்து கொண்டே இருக்கும். இந்த சுழற்சி முறை நடக்க நடக்க உடலில் மாற்றம் ஏற்பட்டுக்கொண்டே இருக்கும். இது உடலில் வயதை அதிகரிக்கும். செல்கள் வயதாகி இறப்பதால்தான் நமக்கு முதிர்ச்சி ஏற்படுகிறது. ஒருவேளை இந்த செல்களை வயதாக விடாமல், இளைமையாகவே வைத்து இருந்தால் எப்படி இருக்கும். அதோடு முதிர்ந்த செல்களை மீண்டும் அதன் தொடக்க நிலையான "எம்பிரியோ" நிலைக்கு கொண்டு சென்றால் எப்படி இருக்கும்?

வயது குறைந்துவிடும்
முதிர்ந்த செல்களை ஊக்கம் கொடுத்து மீண்டும் அதன் தொடக்க நிலைக்கு கொண்டு சென்றால் ஒரு நொடியில் நாமும் இளமையாக மாறிவிடுவோம். இது மிக மிக சிம்பிளான விஷயம்தான். சிம்பிள் அறிவியல்தான். ஆனால் இதை சாதிப்பது என்பது அவ்வளவு சுலபமான விஷயம் கிடையாது. முதலில் விலங்குகளில் இருக்கும் செல்களை இதுபோல புதுப்பித்து மீண்டும் உயிர்பெற வைக்கும் ஆராய்ச்சிகளை செய்ய வேண்டும். அதை சாதித்துவிட்டு பின் பின்விளைவுகளை சோதிக்க வேண்டும். பின் வாய்ப்பு இருந்தால் மனித செல்களிலும் இதே சாதனையை நிகழ்த்த வேண்டும்.

ஆராய்ச்சி
இந்த ஆராய்ச்சியைத்தான் அட்லாஸ் லேப் நிறுவனம் செய்கிறது. இந்த நிறுவனத்தின் ஆராய்ச்சிக்குத்தான் தற்போது ஜெப் பெஸோஸ் கோடிகளை கொட்டிக்கொடுத்துள்ளார். ஏற்கனவே மார்ஸ் பயணம், மார்ஸ் கிரகத்தில் குடியேற்றம் என்று ஜெப்பின் ப்ளூ ஆர்ஜின் நிறுவனம் விண்வெளி ஆராய்ச்சியில் கவனம் செலுத்தி வரும் நிலையில்தான் தற்போது மனிதர்கள் சாகா வரம் பெற வேண்டும் என்றும் துடித்துக் கொண்டு இருக்கிறார். ஏற்கனவே யூனிட்டி டெக்னலாஜி என்ற நிறுவனத்தில் இதேபோல் ஜெப் பெஸோஸ் சாகா வரம் குறித்த ஆராய்ச்சிக்கு முதலீடு செய்துள்ளார். அந்த ஆராய்ச்சியும் தனியாக நடந்து கொண்டு இருப்பது குறிப்பிடத்தக்கது.

எப்படி நடக்கும்?
இந்த அட்லாஸ் லேப் நிறுவனம் ஏற்கனவே இந்திய மதிப்பில் 19 ஆயிரம் கோடி ரூபாய் வரை திரட்டி உள்ளது. இன்னும் பல ஆயிரம் கோடிகளை திரட்டும் முடிவில் உள்ளது. இதில் ஒரு சில ஆராய்ச்சியாளர்களுக்கு மட்டுமே சம்பளம் கொடுக்கப்படும். மற்ற எல்லோருக்கும் முழுக்க முழுக்க சம்பளம் இன்றி ஆராய்ச்சிக்கு மட்டுமே முதலீடு செலவு செய்யப்படும். சம்பளம் இன்றி ஆராய்ச்சி மீது மட்டுமே கவனம் செலுத்தும் ஆராய்ச்சியாளர்களை தேர்வு செய்து இந்த நிறுவனம் வேலைக்கு எடுத்துள்ளது. சான் டியாகோ. பிரிட்டன், ஜப்பான், மத்திய கிழக்கு ஆகிய பல்வேறு பகுதிகளில் ஆராய்ச்சி மையங்களை அமைத்து ஒரே நேரத்தில் ஆராய்ச்சி செய்ய உள்ளனர்.
நோபல் விஞ்ஞானி
இந்த ஆராய்ச்சியில் செல்களை மீண்டும் உயிர்ப்பித்து கொண்டு வருவது எப்படி, மீண்டும் அதை இளைமையாக்குவது எப்படி என்பதில் கவனம் செலுத்தப்படும். நோபல் பரிசு பெற்ற விஞ்ஞானியான ஷின்யா யாமன்கா இந்த ஆராய்ச்சிக்கு தலைமை தங்குவார். இவருக்கு சம்பளம் கிடையாது. இவர் மனித மற்றும் குற்றங்கள் செல்களின் எம்பிரியோவில் ஆராய்ச்சி செய்தவர். அந்த ஆராய்ச்சியின் முடிவில் செல்களில் சிறிய மாற்றங்களை செய்வதன் மூலம் மனிதர்கள் மேலும் 50 ஆண்டுகள் கூடுதலாக வாழ முடியும் என்று கண்டுபிடித்தார்.

நோபல் பின்னணி
இந்த ஆராய்ச்சிக்காக இவருக்கு நோபல் பரிசு வழங்கப்பட்டது. தற்போது அவரின் தலைமையில் இந்த ஆராய்ச்சி தொடங்கப்பட்டுள்ளது. இன்னும் பல பெரிய தலைகள் இதில் விரைவில் முதலீடு செய்ய போகிறார்கள் என்று எதிர்பார்க்கப்படுகிறது. ஒரு பக்கம் கொரோனாவும், காலநிலை மாற்றமும் மனித உயிர்களை வாங்கிக்கொண்டு இருக்கும் நிலையில். இன்னொரு பக்கம் இப்படி மனிதர்கள் வயதாகாமல் இருப்பதற்கான ஆராய்ச்சிகள் நடப்பது வியப்பை ஏற்படுத்தி உள்ளது.















 Click it and Unblock the Notifications
Click it and Unblock the Notifications